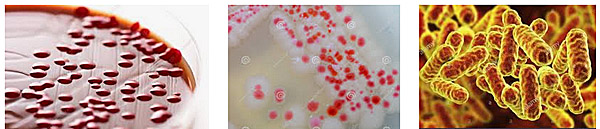
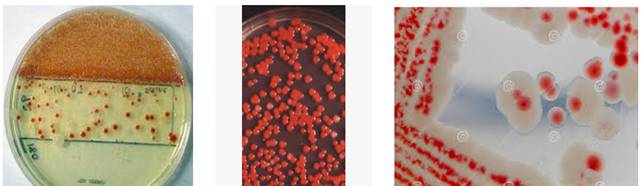
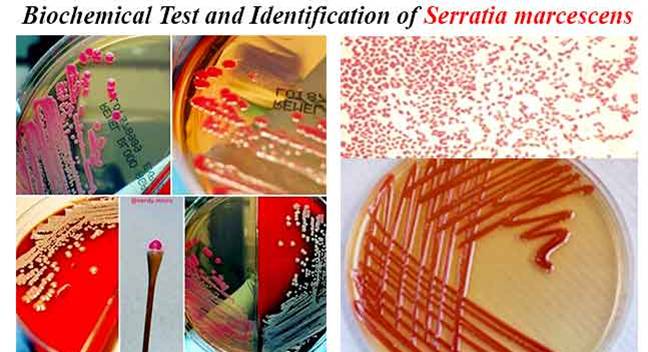

Serratia là một giống trực khuẩn Gram âm, kỵ khí tùy nghi, thuộc họ Enterobacteriaceae. Loài phổ biến nhất là S. marcescens, đồng thời là mầm bệnh duy nhất thường gây ra những trường hợp nhiễm khuẩn bệnh viện. 
Tuy nhiên, một vài chủng hiếm như S. plymuthica, S. liquefaciens, S. rubidaea và S. odoriferae cũng được ghi nhận trong vài trường hợp viêm nhiễm. Những thành viên trong giống Serratia có đặc tính sinh sắc tố đỏ, prodigiosin và có thể phân biệt với cái giống thuộc họ Enterobacteriaceae bởi khả năng sinh ba enzyme duy nhất gồm DNase, lipase và gelatinase. 
Giống Serratia chịu trách nhiệm cho khoảng 2% số ca nhiễm trùng huyết, ít hơn ở đường hô hấp, đường tiết niệu, những vết thương phẫu thuật, da và mô mềm ở bệnh nhân trưởng thành. Viêm màng não do loài S. marcescens lại thường hay bộc phát trong bệnh viêm khớp và viêm nhiễm vết thương ở bệnh nhi. Trong các bệnh viện, chủng Serratia có xu hướng khu trú trong đường tiết niệu và hô hấp hơn là hệ tiêu hóa trong dạ dày và ruột của người trưởng thành. Giống Serratia spp. cũng gây ra bệnh viêm nội tâm mạc và viêm tủy xương đối với những người nghiện ma túy. Những trường hợp viêm khớp do Serratia spp. ghi nhận ở những bệnh nhân ngoại trú nhận được tiêm trong khớp. 

S. marcescens là một loài trực khuẩn hình que, Gram âm, kỵ khí tùy nghi, thuộc họ Enterobacteriaceae. Loài vi khuẩn này thường được tìm thấy trong đất, nước, thực vật và động vật. Phương thức lây truyền của vi khuẩn này bằng cách trực tiếp hoặc bằng ống thông. Loài S. marcescens có thể gây nên bệnh viêm phổi, nhiễm trùng huyết, viêm màng não và áp xe não, nhiễm trùng đường tiết niệu, nhiễm trùng mắt. Chúng xâm nhập vào thức ăn từ môi trường không khí, nước. 
Về phân loại khoa học, Serratia marcescens thuộc giới vi khuẩn, ngành Proteobacteria, lớp Gamma proteobacteria, bộ Enterobacteriales, họ Enterobacteriaceae, giống Serratia và loài S. marcescens (Bizio, 1823).
Về mặt định danh
S. marcescens là một vi sinh vật di động và có thể phát triển trong môi trường có khoảng nhiệt độ từ 5-40°C và trong độ pH từ 5-9. Chúng khác với các loại vi khuẩn Gram- khác bởi khả năng thực hiện thủy phân casein, điều này cho phép nó sinh metalloproteinase ngoại bào, điều này được tin rằng có liên quan đến chức năng tương tác cơ chất từ tế bào đến ngoại bào (cell-to-extracellular matrix interactions). Vì loại vi khuẩn này kỵ khí tùy nghi (facultative anaerobe), có nghĩa là chúng có thể phát triển hoặc trong môi trường có oxy (hiếu khí-aerobic) hay không có oxy (kỵ khí-anaerobic), nó còn có khả năng giảm nitrate dưới điều kiện kỵ khí. Do vậy, test nitrate dương tính vì nitrate thừơng được sử dụng tiếp nhận electron cuối cùng hơn là oxy. S. marcescens cũng biểu hiện thủy phân tyrosine và giáng hóa citrate. 
Citrate được dùng bởi vi khuẩn S. marcescens để sinh pyruvic acid, do đó nó có thể dựa vào citrate như một nguồn carbon và test dương tính citrate. Trong việc xác định vi sinh vật, chúng cũng có thể thực hiện test methyl đỏ xác định nếu một vi sinh vật thực hiện lên men acid phối hợp. Kết quả của S. marcescens trong một test âm tính. 
Thử nghiệm  | Kết quả  | Thử nghiệm  | Kết quả  | 
Nhuộm Gram  | −  | Thủy phân gelatin, 22°C  | +  | 
Oxidase  | −  | Acid từ lactose  | −  | 
Phản ứng sinh indole  | −  | Acid từ glucose  | +  | 
Methyl đỏ  | > 70% −  | Acid từ maltose  | +  | 
Voges-Proskaeur  | +  | Acid từ mannitol  | +  | 
Citrate (Simmons)  | +  | Acid từ sucrose  | +  | 
Phản ứng sinh hydrogen sulfide  | −  | Phản ứng giảm nitrate  | + (với nitrite)  | 
Thủy phân urea  | > 70% −  | Deoxyribonuclease, 25 °C  | +  | 
Khử amin phenylalanine  | −  | Lipase  | +  | 
Lysine decarboxylase  | +  | Sinh hạt sắc tố pigment  | Một số biến thể sinh học sinh màu đỏ  | 
Test di động  | +  | Sinh catalase (24 giờ)  | +  | 
Bệnh sinh học
   |     - Kháng sinh đồcủa vi khuẩn S. marcescens trên thạch Mueller-Hinton.
  - Các thử nghiệm xác định khác với S. marcescens là dựa trên cơ chế có khả năng sinh lactic acid bởi oxi hóa và chuyển hóa lên men. Do đó, S. marcescens là một lactic acid O/F+.  | 
             Trên người, vi khuẩn S. marcescens có thể gây ra nhiễm trùng cơ hội tại một số vị trí, bao gồm nhiễm trùng đường tiểu, đường hô hấp và các vết thương và mắt, ở đó chúng có thể gây viêm kết mạc, viêm mống mắt, viêm nội nhãn và nhiễm trùng tuyến lệ. Vi khuẩn này cũng hiếm khi gây viêm nội tâm mạc hay viêm tủy xương (đặc biệt ở người sử dụng thuốc đường tĩnh mạch), viêm phổi, viêm màng não. Hầu hết các chủng S. marcescens kháng với một số loại kháng sinh vì sự hiện diện các yếu tố R (R-factors), là một loại plasmid có thể mang một hay nhiều gen mã hóa kháng thuốc; tất cả cđược xem như kháng nội sinh với ampicillin, macrolides, thế hệ một của cephalosporins như cephalexin. 
Trên san hô elkhorn, S. marcescens gây bệnh được biết là bệnh mụn trắng (white pox disease). Trên các con tằm, vi khuẩn này có thể gây gây bệnh và tử vong, đặc biệt có liên quan đến các tác nhân khác. Trong các nghiên cứu labo ứng dụng ruồi dấm Drosophila, nhiễm trùng với S. marcescens thường xảy ra. Chúng khi đó có đặc điểm rối loạn sắc tố hay các mảng hay trên ấu trùng, nhộng, hay thường trên các mẫu tinh bột và thực phẩm có đường (đặc biệt quan trọng khi chế biến không phù hợp). 
Một thể lâm sàng hiếm gặp của viêm dạ dày ruột xảy ra trên các trẻ em nhỏ đầu đời do nhiễm trùng S. marcescens. Màu đỏ của tả lót có thể nhìn thấy màu sắc nhầm với tiểu ra máu, điều này có thể khiến cho thầy thuốc lẫn cho người nhà bệnh nhân hoang mang và tìm kiếm nguyên nhân không cần thiết. 
S. marcescens có thể gây ra bệnh lý màu vàng nho hay màu vàng bầu bí, đôi khi dẫn đến các vấn đề nông trang dưa mất mùa nghiêm trọng. 
Giáo sư Jim Burritt và cộng sự tại đại học Wisconsin-Stout đã khám phá một chủng mới S. marcescens trên máu ong (haemolymph) từ đó làm chết hay hư hai cây trồng. Thử nghiệm nghiên cứu của ông ta đã ấn bản và chủng mới có tên là sicaria, điều này có nghĩa là kẻ ám sát ở Latin (assassin in Latin). Giáo sư trình bày S. marcescens sicaria co thể góp phần vào việc thu mật ong trong giai đoạn mùa đông.
Lịch sử nghiên cứu
Vai trò có thể vào thời Trung cổ 
Vì sự hình thành sắc tố đỏ gây ra bởi sự trình diện pigment prodigiosin và khả năng của nó phát triển trên bánh mì, S. marcescens đã biểu hiện như một sự giải thích thuộc vạn vật học thời Trung cổ về sự xuất hiện "kỳ diệu" của máu trên Corporal of Bolsena. Đây như là một dịp quan trọng tiệc lễ tiệc ly của Chúa Gie Su để đề cập ở Bolsena vào năm 1263 do tác giả linh mục Bohemian- người đã nghi ngờ về sự hóa thể hay sự chuyển đổi của bánh mì và rượu bên trong cơ thể và máu của Chúa. Trong suốt buổi lễ của Chúa Eucharist dừơng như chảy máu và mỗi lần linh mục lau sạch vết máu thì lại càng xuất hiện. Sự kiện này kỷ niệm hay đánh dấu một lối vẽ trên tường của cung điện Apostolic Palace tại thành phố Vatican được vẽ bởi Raphael. 
Khám phá
S. marcescens được khám phá vào năm 1819 bởi tác giả là một dược sỹ ở Bắc Ý có tên là Bartolomeo Bizio như một tác nhân của giai đoạn thay đổi màu sắc đỏ như máu (blood-red discoloration) của cháo hạt dẻ ở thành phố Padua. Bizio đặt tên vi sinh vật 4 năm sau đó là Serafino Serrati, một nhà vật lý đã phát triển tàu thủy chạy bằng hơi nước; tính ngữ marcescens (tiếng Latin có nghĩa là suy tàn, hỏng) được chọn vì sự thối rửa nhanh chóng của sự hình thành sắc tố (sự quan sát của Bizio dẫn ông ta tin rằng vi sinh vaatjh này làm hư hại thành chất giống như một chất nhầy khi đạt đến độ trưởng thành). Serratia sau đó được đặt tên lại là Monas prodigiosus và Bacillus prodigiosus trước khi tên gốc Bizio' được phục hồi vào những năm 1920.
Sử dụng và sử dụng sai
Vai trò của thử nghiệm trong chiến tranh sinh học
Mãi đến những năm 1950, vi khuẩn S. marcescens mới được tin là sai lầm vì trước đó họ nghĩ rằng chúng là vi khuẩn hoại sinh và không gây bệnh (nonpathogenic "saprophyte") và sự chuyển màu đỏ đã được sửu dụng trong các thực nghiệm ở trừơng học để truy tìm nhiễm trùng. Trong thời kỳ chiến tranh lạnh, người ta sử dụng chúng như một tác nhân giống như chiến tranh sinh học ở trong Quân đội Mỹ, điều này đã được nghiên cứu trong các thử nghiệm thực địa như một thành phần vi khuẩn gây bệnh nhiễm trùng thường gặp ở thỏ và gặm nhấm (tularemia bacterium) và khi đó xem như vũ khí. 
Vào ngày 26-27/9/1950, Hải quân Mỹ tiến hành một thí nghiệm bí mật có tên gọi là "Operation Sea-Spray" trong đó các quả bóng được làm đầy bởi vi khuẩn S. marcescens được ly giải và nổ tung các vùng nông thôn của vùng vịnh San Francisco tại California. Mặc dù, quân đội Hải quân Mỹ sau đó đã yêu cầu và cho rằng vi khuẩn vô hại, bắt đầu vào ngày 29/11 có 11 bệnh nhân tại bệnh viện địa phương phát hiển các triệu chứn nghiêm trọng, hiếm gặp ở trên đừơng tiết niệu. Một trong những bệnh nhân đau đớn là Edward J. Nevin đã tử vong. Các ca viêm phổi ở San Francisco cũng tăng sau khi lý giải S. marcescens. 
Vi khuẩn kích thích gây nhiễm trùng này và các ca tử vong chưa bao giờ bị quy kết là do chúng cả. Con trai của Nevin và ông nội đã lên vụ kiện chống lại chính phủ từ năm 1981-1983 trên nền tảng “miễn dịch” và cơ hội mà vi khauanr được phun ra đã gây ra cái chết của Nevin là rất nhỏ. Vi khuẩn cũng phối hợp với phenol và có dạng như vi khuẩn than, được phun khắp phía nam Dorset bởi các nhà khoa học quân đội Anh và quân đội Mỹnhư một phầncủa thử nghiệm DICE thực hiện từ năm 1971-1975. 
Từ những năm 1950, S. marcescens đã tăng đều như một nguyên nhân gây nhiễm trùng ở người với nhiều chủng đề kháng với nhiều loại kháng sinh khác nhau. Chỉ định lần đầu tiên của vấn đề với vaccine cúm sinh ra bởi Chiron Corporation vào năm 2004 liên quan đến nhiễm vi khuẩn S. marcescens. 
Những mũi tiêm làm ô nhiễm
Vào đầu những năm 2008, Cục FDA của Mỹ đã cho ra thông báo toàn quốc về một dung dịch có tên Pre-Filled Heparin Lock Flush Solution USP. Các mũi tiêm heparin tĩnh mạch đã được tìm thấy có nhiễm vi khuẩn S. marcescens, dẫn đến nhiễm trùng trên các bệnh nhân. Trung tâm CDC Mỹxác định sự phát triển của vi khuẩn S. marcescens từ một số bơm tiêm chưa sử dụng, chưa mở nắp nhiễm. 
S. marcescens cũng được tìm thấy có liên quan đến 19 ca tại bệnh viện Alabama vòa năm 2011, gồm 10 ca đã tử vong. Tất cả bệnh nhân liên quan đã được chỉ định dinh dưỡng đường ngoài miệng vào thời điểm đó và đây là cuộc điều tra có thể đó là nguồn nhiễm và gây ra vụ dịch?. 
Truy tìm nguồn nước ngầm
Vì khả năng phát triển của vi khuẩn này trên các đĩa thạch, bải cỏ nhuộm màu và sự tồn tại của giai đoạn đặc thù với vi khuẩn S. marscecens, người ta sử dụng để truy tìm dòng nước tại hệ thống đã vôi Karst. Số lượng được biết của phage đỏ vào trong hệ thống nước Karst và dòng chảy được giám sát theo phương thức lấy mẫu nước nhỏ để xét nghiệm theo kỹ thuật cổ điển tại các thời điểm cố định. 
Trong phòng xét nghiệm, các mẫu được đỏ vào vi khuẩn S. marscecens và ủ. Các mảng không màu trên các mảng cỏ cho thấy sự hiện diện của các thể thực khuẩn. Phương pháp này cho rằng có độ nhạy cao ở mức pha loãng vì khả năng phát hiện các phần tử trong thể thực khuẩn đơn. 

Hiện diện của vi khuẩn S. marcescens gây màu đỏ bất thường trong thực phẩm
Năm 1819, Bartolomeo Bizio, một dược sĩ từ Padua, Ý đã phát hiện và đặt tên vi khuẩn Serratia mercescens khi ông xác định được vi khuẩn là nguyên nhân của một sự đổi màu máu kỳ diệu của Polenta (bột bắp). Ban đầu nó được xem là vi khuẩn vô hại và thường sử dụng như một dấu ấn trong ngành sinh học vì có thể dễ dàng nhận ra màu đỏ khuẩn lạc của nó (năm 1896). Mãi đến sau năm 1950, chính phủ Mỹ đã làm thử nghiệm với Serratia marcescens và thấy những ảnh hưởng bất lợi do vi khuẩn này gây ra. 
Vi khuẩn Serratia marcescens thường có trong đất, nước, thực vật và động vật. Chúng xâm nhập vào thức ăn từ môi trường không khí, nước, người bệnh. Phương thức lây truyền của vi khuẩn này là lây trực tiếp hoặc bằng ống thông. Chúng có thể gây nên bệnh viêm phổi, nhiễm trùng huyết, viêm màng não và áp xe não, nhiễm khuẩn bệnh viện (0,5% số ca), nhiễm trùng đường tiết niệu, nhiễm trùng mắt.
Trong 9 tháng đầu năm 2016, nhiệt độ trên cả nước không nóng quá mà cũng không lạnh quá, dao động trong khoảng 20-37°C đây nhiệt độ lý tưởng rất lý tưởng cho các loại vi khuẩn phát triển trong đó có vi khuẩn Serratia marcescen. Theo thống kê từ năm 2014 đến nay trên cả nước xuất hiện khá nhiều hiện tượng thực phẩm để qua đêm chuyển sang màu đỏ bất thường.
Tại tỉnh Quảng Trị cũng vi khuẩn Serratia marcescen cũng đã xuất hiện tại các hộ gia đình. Vào ngày 07/9/2016, chị Hậu ở xã Cam An, huyện Cam Lộ, tỉnh Quảng Trị mua thịt lợn của bà Mẫn tại chợ Ngã Tư Sòng đem về luộc ăn, phần thịt còn dư lại trong bữa ăn bà Hậu cất trong tủ lạnh mai ăn tiếp, sáng hôm sau bà Hậu phát hiện miếng thịt đã đổi màu bất thường. Sau đó chi cục ATVSTP Quảng Trị gửi mẫu xét nghiệm và có kết quả dương tính với Serratia marcescens 
Ảnh từ Chi cục An toàn vệ sinh thực phẩm Quảng Trị.
Trước đó một số địa phương trên địa bàn cả nước cũng xảy ra khá nhiều trường hợp tương tự như Quảng Trị. Vào ngày 30/03/2016, Chị B. ở Cam An-Cam Lộ, tỉnh Quảng Trị  mua thịt và xương lợn tại quầy chị H. chợ N. về nấu ăn, phần thịt thừa còn lại chị đem bảo quản ở nhiệt độ phòng, một ngày sau chị B. định mang số thịt đó ra xào rau thì thấy miếng thịt đã chuyển sang màu đỏ bất thường.
Ngày 28/3/2014, chị Nguyễn Thị A. trú tại TP. Vinh, Nghệ An đi chợ mua 3 lạng thịt về ăn. Sau khi luộc chín, miếng thịt không có biểu hiện gì khác lạ. Buổi trưa hôm đó gia đình chỉ ăn hết một phần, phần còn lại chị A. bỏ vào ngăn mát của tủ lạnh cất giữ. Đến chiều ngày hôm sau, chị A. mang miếng thịt lợn ra thì phát hiện thịt xuất hiện những nốt màu đỏ, nước chảy ra có màu hồng nhạt. Xét nghiệm và có kết quả dương tính với Serratia marcescens. Ngày 15/4/2014, Chi cục Quản lý chất lượng Nông lâm sản và Thuỷ sản Nghệ An cử cán bộ thực hiện lấy mẫu đột xuất sản phẩm trứng vịt chợ Q., TP. Vinh đem đi xét nghiệm và có kết quả dương tính với Serratia marcescens.
Ngày 14/03/2016 theo Báo Quảng Ngãi cũng xuất hiện trường hợp tương tự dương tính với Serratia marcescens. Ngày 25/03/2016 ông T. ở huyện Bình Chánh, TP. Hồ Chí Minh, phản ánh phát hiện cơm trong nồi đổi từ màu trắng sang đỏ quạch như máu sau khi để qua đêm. Gạo được ông mua gần chợ Bình Chánh. Hàng xóm thấy kỳ lạ nên lấy một ít gạo về nấu thử, để qua hôm sau cũng thấy hiện tượng chuyển sang màu đỏ tương tự. Theo ý kiến của các nhà khoa học, thực phẩm chuyển sang màu đỏ bất thường là do sau khi chế biến xong, thực phẩm không được sử dụng hoặc bảo quản không đúng cách tạo điều kiện cho vi sinh vật phát triển trong đó có vi khuẩn Serratia marcescens. Đây là chủng vi khuẩn với sắc tố màu đỏ đặc trưng rất dễ chẩn đoán và phát hiện trong phòng xét nghiệm và ít khi bỏ sót. Thử nghiệm được thực hiện trên mẫu bệnh phẩm trong điều kiện nhiệt độ 250C đã thu được khuẩn Serratia marcescens (còn gọi là khuẩn lạc - vi khuẩn nuôi cấy được trên mẫu thịt) có màu đỏ, khiến thịt biến thành màu đỏ tươi. 
Qua những sự việc nói trên, để đảm bảo sức khỏe cho bản thân và gia đình, chúng ta cần phải vệ sinh cá nhân tốt, thường xuyên khử trùng bề mặt khu vực chế biến thực phẩm, bàn ăn, tủ lạnh ... bằng dung dịch cloramin B. Thực hiện ăn chín, uống sôi, ăn ngay sau khi chế biến xong, bảo quản thực phẩm theo đúng quy trình, tuyệt đối không sử dụng các loại thực phẩm có màu, mùi, vị bất thường.
TÀI LIỆU THAM KHẢO
1.IZIO (B.): Lettera di Bartolomeo Bizio al chiarissimo canonico Angelo Bellani sopra il fenomeno della polenta porporina. Biblioteca Italiana o sia Giornale di Letteratura, Scienze e Arti (Anno VIII), 1823, 30, 275-295. 
2.Genus Serratia. List of Prokaryotic Names with Standing in Nomenclature (LPSN). Retrieved 6 June 2016. 
3.Hicks, Randall. Pronunciation Guide to microorganisms. University of Minnesota. 
4.Serratia marcescens. (2011). Retrieved from https://microbewiki.kenyon.edu/index.php/Serratia_marcescens 
5.Hejazi A; Falkiner FR (1997). Serratia marcescens. J Med Microbiol. 46 (11): 903-12. 
6.Auwaerter P (2007). Serratia species. Point-of-Care Information Technology ABX Guide. Johns Hopkins University. Retrieved 13 December 2008. 
7.Williamson NR, Fineran PC, Gristwood T, Leeper FJ (2006). The biosynthesis and regulation of bacterial prodiginines". Nature Reviews Microbiology. 4 (12): 887-899. 
8.Aryal, S. (2018). Biochemical Test and Identification of Serratia marcescens. Retrieved from https://microbiologyinfo.com/biochemical-test-and-identification/ 
9.Serratia marcescens. (2011). Retrieved from https://microbewiki.kenyon.edu/Serratia_marcescens 
10.Serratia marcescens. (2011). Retrieved from https://microbewiki.kenyon.edu/index.php/Serratia_marcescens 
11."Serratia". Soil Microbiology, Environmental Microbiology BIOL/CEEE/CSES 4684. Virginia Tech. 2004. Archived from the original on 6 April 2005. 
12.Bergey's Manuals of Determinative Bacteriology, by John G. Holt, 9th ed. Lippincott Williams & Wilkins, 15 January 1994. p. 217 
13.Pathogen Safety Data Sheets: Infectious Substances-Serratia spp. Public Health Agency of Canada. 30 April 2012. Retrieved 28 April 2018. 
14.Serratia marcescens seton implant infection & orbital cellulitis. EyeRounds.org. Retrieved 6 April 2006. 
15.Patterson KL, Porter JW, Ritchie KB, et al. (2002). The etiology of white pox, a lethal disease of the Caribbean elkhorn coral, Acropora palmata. Proc Natl Acad Sci USA. 99 (13): 8725-30. 
16.Vasantharajan VN, Munirathnamma N (1978). Studies on Silkworm Diseases III - Epizootiology of a Septicemic Disease of Silkworms Caused by Serratia marcescens". Journal of the Indian Institute of Science. 60 (4). Retrieved 14 July 2016. 
17.The Red Diaper Syndrome. Rev Chil Paediatr. 1960 Jul;31:335-9 
18.Cucurbit Yellow Vine Disease (CYVD) In Connecticut. University of Connecticut Integrated Pest Management. Archived from the original on 25 May 2012. 
19.Review of Bee Health Decline. Research buzz: Professor, students identify bacterium that may kill honey bees. www.thecre.com. Retrieved 2 January 2017. 
20.Biology Professor Discovers New Clue About What's Killing Bees. NBC News. Retrieved 2 January 2017. 
21.Bennett JW; Bentley R (2000). Seeing red: The story of prodigiosin. Adv Appl Microbiol. 47:1-32. 
22.The Mass at Bolsena by Raphael". Vatican Museums. Retrieved 3 May 2006. 
23.Sehdev PS; Donnenberg MS (1999). "Arcanum: The 19th-century Italian pharmacist pictured here was the first to characterize what are now known to be bacteria of the genus Serratia". Clin Infect Dis. 29(4):770, 925. 
24.Bizio's original report was translated into English in 1924, and published in the Journal of Bacteriology. See Merlino CP (1924). Bartolomeo Bizio's Letter to the most Eminent Priest, Angelo Bellani, Concerning the Phenomenon of the Red Colored Polenta. J Bacteriol. 9 (6): 527-43. 
25.How the U.S. Government Exposed Thousands of Americans to Lethal Bacteria to Test Biological Warfare". Democracy Now!. 13 July 2005. Retrieved 6 June 2016. 
26.Serratia has dark history in region. SFGate. 31 October 2004. Retrieved 14 July 2016. 
27.Cole, Leonard A. (1988). Clouds of Secrecy: The Army's Germ-Warfare Tests Over Populated Areas. (Foreword by Alan Cranston.). Totowa, New Jersey: Rowman & Littlefield. ISBN 0-8476-7579-3. 
28.Regis, Ed. The Biology of Doom : America's Secret Germ Warfare Project. Diane Publishing Company. ISBN 0-7567-5686-3. 
29.Barnett, Antony (2002). Millions were in germ war tests. The Guardian. 
30.AM2 PAT, Inc. Issues Nationwide Recall of Pre-Filled Heparin Lock Flush Solution USP (5 mL in 12 mL Syringes) 
31.Nisbet, Robert (2011). Drip Feeds Linked To US Hospital Deaths. 
32.FDA. Retrieved 31 March 2011. 
33.Jofre J. Goldscheider N; Drew D (eds.). Methods in Karst Hydrology. International Association of Hydrogeologists -IAWPRC. pp. 138-139. 
34.Horan N J; Naylor P J (1988). Water Pollution Control in Asia -The potential of bacteriophage to act as tracers of water movement. Pergamon Press. pp. 700-704. ISBN 0 08 0368840.
35.Khanna A, Khanna M, Aggarwal A. (2013). Serratia marcescens- a rare opportunistic nosocomial pathogen and measures to limit its spread in hospitalized patients. J Clin Diagn Res. 2013 Feb;7(2):243-6. 
36.Steppberger K, Walter S, Claros MC, Spencker FB, Kiess W, Rodloff AC, Vogtmann C.Nosocomial neonatal outbreak of Serratia marcescens--analysis of pathogens by pulsed field gel electrophoresis and polymerase chain reaction. Infection. 2002 Oct;30(5):277-81.
37.Endoh M, Okuno R, Mukaigawa J, Shimojima Y, Murata I (2004). Two nosocomial outbreaks of sepsis caused by Serratia marcescens, which occurred in July 1999 and January 2002--Tokyo]. Kansenshogaku Zasshi. 2004 Apr;78(4):295-304. Japanese. 
38.Archibald LK, Corl A, Shah B, Schulte M, Arduino MJ, Aguero S, Fisher DJ, Stechenberg BW, Banerjee SN, Jarvis WR. Serratia marcescens outbreak associated with extrinsic contamination of 1% chlorxylenol soap.Infect Control Hosp Epidemiol. 1997 Oct;18(10):704-9.
39.Alfizah H, Nordiah AJ, Rozaidi WS. Using pulsed-field gel electrophoresis in the molecular investigation of an outbreak of Serratia marcescens infection in an intensive care unit. Singapore Med J. 2004 May;45(5):214-8.
40.Takahashi H, Kramer MH, Yasui Y, Fujii H, Nakase K, Ikeda K, Imai T, Okazawa A, Nosocomial Serratia marcescens outbreak in Osaka, Japan, from 1999 to 2000. Infect Control Hosp Epidemiol. 2004 Feb;25(2):156-61.
41.Ktari S, Mahjoubi F, Mnif B, Kallel H, Bouaziz M, Hammami A. Investigation of three nosocomial outbreaks of Serratia marcescens in an intensive care unit in Sfax-Tunisia. Tunis Med. 2010 Jul;88(7):501-6. French. 
42.Troillet N, Carmeli Y, Venkataraman L, DeGirolami P, Samore MH. Epidemiological analysis of imipenem-resistant Serratia marcescens in hospitalized patients. J Hosp Infect. 1999 May;42(1):37-43.
43.Chiang PC, Wu TL, Kuo AJ, Huang YC, Chung TY, Lin CS, Leu HS, Su LH. Outbreak of Serratia marcescens postsurgical bloodstream infection due to contaminated intravenous pain control fluids. Int J Infect Dis. 2013 Sep;17(9):e718-22. 
44.de Boer MG, Brunsveld-Reinders AH, Salomons EM, Dijkshoorn L, Bernards AT, van den Berg PC, van den Broek PJ. Multifactorial origin of high incidence of Serratia marcescens in a cardio-thoracic ICU: analysis of risk factors and epidemiological characteristics.J Infect. 2008 Jun;56(6):446-53. 
45.Mahlen SD. Serratia infections: from military experiments to current practice. Clin Microbiol Rev. 2011 Oct;24(4):755-91. 
46.Šiširak M, Hukić M.An outbreak of multidrug-resistant Serratia marcescens: the importance of continuous monitoring of nosocomial infections. Acta Med Acad. 2013;42(1):25-31. 
47.Ulu-Kilic A, Parkan O, Ersoy S, Koc D, Percin D, onal O, Metan G, Alp E.Outbreak of postoperative empyema caused by Serratia marcescens in a thoracic surgery unit. J Hosp Infect. 2013 Nov;85(3):226-9. 
48.Leng P, Huang WL, He T, Wang YZ, Zhang HN. Outbreak of Serratia marcescens postoperative infection traced to barbers and razors. J Hosp Infect. 2015 Jan;89(1):46-50. 
49.Sartor C, Jacomo V, Duvivier C, Tissot-Dupont H, Sambuc R, Drancourt M. Nosocomial Serratia marcescens infections associated with extrinsic contamination of a liquid nonmedicated soap. Infect Control Hosp Epidemiol. 2000 Mar;21(3):196-9.
50.Rabier V, Bataillon S, Jolivet-Gougeon A, Chapplain JM, Beuchée A, Bétrémieux P.Hand washing soap as a source of neonatal Serratia marcescens outbreak. Acta Paediatr. 2008 Oct;97(10):1381-5. 
51.Coria-Jiménez VR, Villa-Tanaka L, Ortíz-Torres C. Partial characterization of Serratia marcescens nosocomial strains. Arch Invest Med (Mex). 1991 Jul-Dec;22(3-4):273-8.